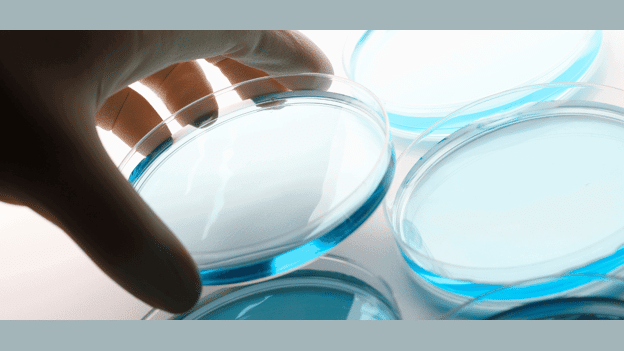

Featured
Microbial protein for people with modified diets
Using microbes to grow protein could help reduce the need for farmed meat and improve sustainability
Want to explore this innovation?
Start a free trial and get 7 days access to our global innovation database, AI-powered scouting tools, and expert insights. No commitment required
Start free trial View plans
If you are an existing member, login here